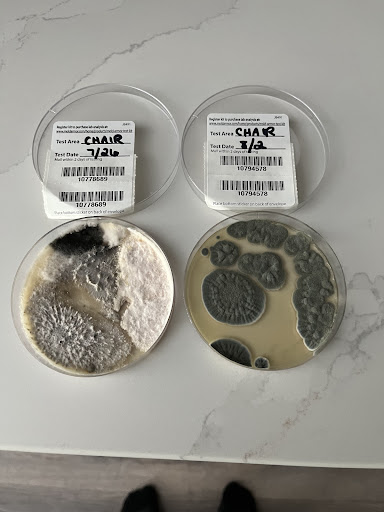

Bassett Furniture things to do, attractions, restaurants, events info and trip planning

Basic Info
Bassett Furniture
11385 Legacy Ave, Palm Beach Gardens, FL 33410
3.9(41)
Closed
Save
spot
spot
Ratings & Description
Info
Cultural
Entertainment
Accessibility
attractions: Eissey Campus Theatre, restaurants: The Capital Grille, Cool'A Fishbar, The Great Greek Mediterranean Grill - Palm Beach Gardens, FL, Sal's Italian Ristorante, Five Guys, Avocado Cantina, Dil’s Daily, Yard House, Jimmy John's, Downtown Palm Beach Gardens, local businesses: Men's Wearhouse, Jared Jewelers, Ethan Allen, My-Lashes Eyelash Extensions, Best Buy, EōS Fitness, Petco, Patio Shoppe of The Palm Beaches, Blo Blow Dry Bar Palm Beach Gardens, UHealth Palm Beach Gardens
 Learn more insights from Wanderboat AI.
Learn more insights from Wanderboat AI.Phone
(561) 624-4242
Website
stores.bassettfurniture.com
Open hoursSee all hours
Wed10 AM - 6 PMClosed
Plan your stay

Pet-friendly Hotels in Palm Beach Gardens
Find a cozy hotel nearby and make it a full experience.

Affordable Hotels in Palm Beach Gardens
Find a cozy hotel nearby and make it a full experience.

The Coolest Hotels You Haven't Heard Of (Yet)
Find a cozy hotel nearby and make it a full experience.

Trending Stays Worth the Hype in Palm Beach Gardens
Find a cozy hotel nearby and make it a full experience.
Reviews
Live events

Saddle up for Loxahatchee trails
Wed, Jan 28 • 10:00 AM
Palm Beach County, Florida, 33470
View details

Snorkel reefs with sea turtles
Wed, Jan 28 • 9:00 AM
Riviera Beach, Florida, 33404
View details

Candlelight: Coldplay & Imagine Dragons
Sat, Jan 31 • 8:30 PM
301 S Olive Avenue, West Palm Beach, FL, 33401
View details
Nearby attractions of Bassett Furniture
Eissey Campus Theatre

Eissey Campus Theatre
4.8
(34)
Open 24 hours
Click for details
Nearby restaurants of Bassett Furniture
The Capital Grille
Cool'A Fishbar
The Great Greek Mediterranean Grill - Palm Beach Gardens, FL
Sal's Italian Ristorante
Five Guys
Avocado Cantina
Dil’s Daily
Yard House
Jimmy John's
Downtown Palm Beach Gardens

The Capital Grille
4.7
(704)
$$$$
Closed
Click for details

Cool'A Fishbar
4.6
(292)
$$
Closed
Click for details

The Great Greek Mediterranean Grill - Palm Beach Gardens, FL
4.5
(444)
$
Closed
Click for details

Sal's Italian Ristorante
4.1
(262)
$
Closed
Click for details
Nearby local services of Bassett Furniture
Men's Wearhouse
Jared Jewelers
Ethan Allen
My-Lashes Eyelash Extensions
Best Buy
EōS Fitness
Petco
Patio Shoppe of The Palm Beaches
Blo Blow Dry Bar Palm Beach Gardens
UHealth Palm Beach Gardens

Men's Wearhouse
4.5
(254)
Click for details

Jared Jewelers
4.6
(104)
Click for details

Ethan Allen
4.4
(81)
Click for details

My-Lashes Eyelash Extensions
4.9
(68)
Click for details